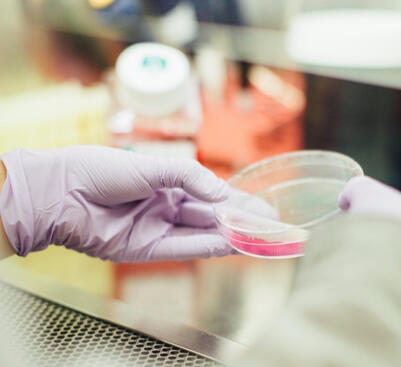
Biología

Crea
tu primer
videojuego
en casa
Crea tu primer videojuego en casa es una experiencia de aprendizaje para niños y niñas de 10 a 13 años, en que aprenderán a crear su primer videojuego además de ser iniciados en el mundo de la creación digital.Nuestro enfoque de aprendizaje basado en proyectos brinda una experiencia divertida y atractiva donde los niños pueden expresar su creatividad, aprender conceptos básicos de creación de software, aplicar conceptos de física y matemáticas asi como incrementar su vocabulario en inglés.

Usamos una plataforma simple, 100% web, no se requiere instalar programas adicionales, y les permite aprender de forma lúdica los rudimentos de la programación de software usando un lenguaje de bloques, similares a los bloques de construcción playgo, mecano, etc.Crea tu primer videojuego en casa está diseñado con el enfoque de aprendizaje basado en proyectos de forma que la evidencia de aprendizaje la genera el propio aprendiz durante su entrenamiento.Crea tu primer videojuego en casa es una forma divertida de conectar con su creatividad interior, de honrar su aprendizaje como ser humano.

Ocho sesiones

Certificado digital

Insignia digital

Material de repaso
Estos son los beneficios del aprendizaje que obtendrá tu hijo, tu hija. Al finalizar las sesiones de aprendizaje en Crea tu primer videojuego en casa tu hijo podrá:

Crear su primer videojuego en casa
El pilar de su experiencia de aprendizaje

Expresar su creatividad usando la tecnologia como medio
La creatividad es vital para relacionarnos con el mundo

Aprender las bases de la creación de software
El software se esta "comiendo al mundo".
Marc Adreesen

Diseñar escenarios, personajes y reglas del juego
Establece las bases de un pensamiento computacional

Practicar y aprender nuevas palabras en Inglés
Expande sus posibilidades de comunicación

Conocer y aplicar conceptos de Física
Para crear sus mundos virtuales parte por entender como funciona el mundo físico

Conocer y aplicar conceptos de Matemática
Una matematica aplicada al acto creativo

Imaginar, crear y presentar un Proyecto Final
Un cierre de experiencia que jamás olvidará en su vida
NUEVO GRUPO
Inicio: 7 de febrero de 2026
Término: 28 de febrero de 2026
Duración:
8 a 10 años / Kids / 8 horas
11 a 13 años / Teens / 12 horas
Frecuencia: 1 sesion por semana
Modalidad: Online via Zoom
Somos un equipo de apasionados por el aprendizaje integral. Nuestro potencial creativo es infinito, es lo que nos hace verdaderamente humanos. Estamos felices de poner nuestros talentos a tu servicio.Nuestra misión es Descubrir y cultivar talento humano a traves de la indagación creativa y la investigación aplicada.



“¿Te imaginas a donde puede llegar tu hijo, tu hija al aprender a crear su primer videojuego en casa?”El Futuro requiere tanto de (re)conocer, honrar y celebrar nuestra experiencia humana como de aprender ciencia, tecnologia, ingeniería, matemática y arte (STEAM).

Electrónica
Biología

Tecnología

Diseño

Ingeniería
¿Puedo usar un telefono movil o una tablet para asistir al taller?
No. En nuestra experiencia no permiten que el aprendiz pueda concretar de forma satisfactoria sus proyectos. Es por ello que se requiere una laptop o PC con Windows, Mac OS o Linux y un navegador actualizado. En adicion a ello un mouse y webcam o camara integrada.¿Debo instalar algun software adicional?
Es necesario que tengas
A. la version mas reciente de Google Chrome, Mozilla Firefox, Microsoft Edge o Apple Safari.
B. la version mas reciente de Zoom¿Que lenguaje de programacion usarán?
Usaremos Blockly una libreria de bloques visuales de programacion creada por Google y que esta integrada dentro de la herramienta Makecode Arcade creada por Microsoft.¿Que tiempo de duración son las sesiones?
Son sesiones de
2 horas para niños de 8 a 10 años
3 horas para niños de 11 a 13 años

Libera la creatividad de tus hijos
Crea tu primer videojuego en casa es una experiencia de aprendizaje para niños y niñas de 8 a 13 años, en que aprenderán a crear su primer videojuego, serán iniciados en el mundo de la creación digital, aprenderán conceptos básicos de creación de software, aplicarán conceptos de física y matemáticas asi como incrementarán su vocabulario en inglés.Nuestro enfoque de aprendizaje basado en proyectos genera un espacio en que los niños pueden expresar su creatividad.Una experiencia divertida, atractiva e inolvidable!
©2021-2026 Estación Maker
Experiencias

Los videojuegos no solo son una poderosa forma de expresion creativa sino tambien pueden ser una herramienta de aprendizaje inmersivo. El juego forma parte de lo mas innato que tenemos todos los humanos pues nos conecta al momento presente con nuestros pensamientos, nuestra corporalidad y nuestras emociones.
Crea tu primer videojuego en casa es una experiencia de aprendizaje para niños y niñas de 10 a 13 años, en que aprenderán a crear su primer videojuego además de ser iniciados en el mundo de la creación digital.
“¿Te imaginas a donde puede llegar tu hijo, tu hija al aprender a crear su primer videojuego en casa?”
Estación Maker




"Solo se ve bien con el corazón, lo esencial es invisible a los ojos". Antoine de Saint-Exupéry.
Estación Maker
Somos un equipo de apasionados por el aprendizaje integral. Nuestro potencial creativo es infinito. Es lo que nos hace humanos.
Ponemos nuestros talentos a tu servicio.
Mirar con una mente y corazón abiertos ❤️
Nuestro enfoque esta orientado en el aprendizaje integral, aquel que reconoce lo humano desde un equilibrio armónico entre lo racional, lo emocional, lo corporal y lo trascendente.
Aprendizaje divertido y con rigor analítico 📈
Realizamos investigaciones de alta calidad, respaldamos el uso de datos y pruebas, y desarrollamos herramientas que mejoren la enseñanza y aceleren y profundicen el aprendizaje.
Autoliderazgo y expresión del Ser 🌱
Nuestras experiencias de aprendizaje tienen como fin, honrar y potenciar la experiencia humana, fomentar las capacidades de autoconocimiento y expresión del Ser.
Nuestro compromiso
Contribuir a liberar nuestras capacidades innatas. En cada uno de nosotros hay una voz latente esperando que nos atrevamos a mostrarla y ser en el mundo.
Nuestra misión
Descubrir y cultivar talento humano a traves de la indagación creativa y la investigación aplicada.
Si estas comprometido con la transformación, queremos conocerte y que seas parte de nuestro equipo. Tenemos varias posiciones abiertas en Diseño, Ingenieria, Aprendizaje y Tecnología. Escribenos a
apasionados@estacionmaker.xyz
En contacto
Estamos encantados de recibir cualquier comunicación a traves de los siguientes medios.